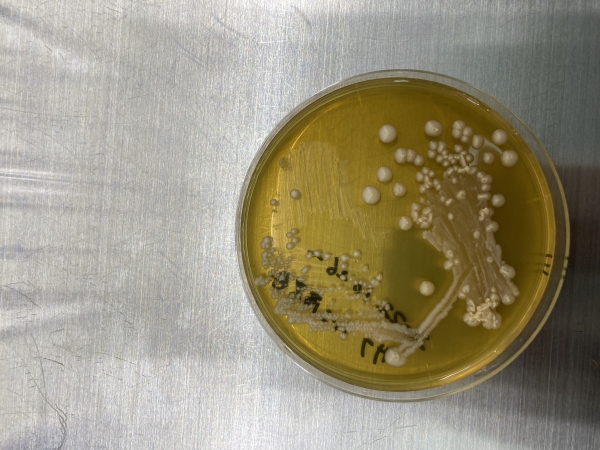
...

イベントNo:2025050011
【8月7日】ビブリオ・自然のふしぎ研究室「微生物をみる、知る、アートする」
終了開催日:2025-08-07
実験、体験を交えた、農・食・自然がテーマのミニ講義!
今回のテーマは、パン酵母や納豆菌などの「微生物」です。
参加者お一人ごとにお申込みください。
* 小学3年生以下のお子様は、保護者の同伴をお願いします。
開催日時
2025-08-07
15:00 ~ 16:00
15:00 ~ 16:00
場所
食文化体験スペース
イベントの種類
セミナー・講座
申込条件
公開(申込あり)
申込方法
先着順
講師
河井重幸先生(石川県立大学生物資源工学研究所)
主催団体
石川県立図書館
定員
12人
申込開始日時
2025-05-24 00:00
締切日時
2025-08-07 00:00

石川県立図書館の利用者登録とパスワード発行がお済の方は、右上のログインボタンを押下していただき、ログインしてからイベント申し込みを行うと、マイイベントで申込み済イベントの一覧を確認することができます。※ログインせずに申し込むこともできます。
石川県立図書館の利用者登録とパスワード発行がお済の方は、右上のメニューよりログインボタンを押下していただき、ログインしてからイベント申し込みを行うと、マイイベントで申込み済イベントの一覧を確認することができます。※ログインせずに申し込むこともできます。
申込期間外です